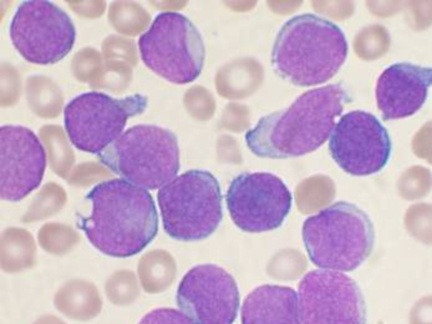

Александра Брутер: Генотерапия лейкоза: первые результаты трехлетних клинических испытаний

 Генотерапия при лейкозе World Bank Photo Collection/Flickr.com
Генотерапия при лейкозе World Bank Photo Collection/Flickr.com В июле 2010 года в Пенсильванском университете начались клинические испытания нового метода противораковой терапии, позволившего за прошедшие два с половиной года спасти или существенно продлить жизни пациентов, у которых уже не оставалось надежды в рамках классических подходов.
Микропрепарат костного мозга больного острой В-лимфоцитарной лейкобластной лейкемией
Микропрепарат костного мозга больного острой В-лимфоцитарной лейкобластной лейкемией Результат: у троих взрослых пациентов с хроническим лейкозом наступила полная ремиссия, у четверых – частичное улучшение, двоим лечение не помогло, а еще к одному пациенту терапию применили слишком недавно, чтобы делать какие-то выводы. Двое участников клинических испытаний были детьми. В одном случае после улучшения наступил рецидив. Во втором – у восьмилетней Эммы Уайтхед, заболевшей острым миелобластным лейкозом в 2010 году, – наступила полная ремиссия, продолжающаяся уже около 10 месяцев.
Подход к лечению лейкозов, применяемый врачами из Филадельфии, заключается в том, что они «обучают» собственные клетки иммунной системы пациента распознавать и убивать раковые клетки.
Маленькие убийцы
Хронический лимфолейкоз – злокачественное заболевание, при котором в организме происходит размножение и накопление атипичных зрелых B-лимфоцитов. Острый лимфобластный лейкоз – более тяжелое заболевание, поскольку вызывается неконтролируемым размножением незрелых B- или Т-лимфоцитов (клеток-предшественников), способных размножаться быстрее и агрессивнее.
 Лимфоцит, окруженный красными кровяными тельцами
Лимфоцит, окруженный красными кровяными тельцами В клинических испытаниях принимали участие только те пациенты, у которых острый лимфобластный лейкоз вызывался размножением предшественников B-лимфоцитов. Большинство зрелых B-лимфоцитов и их предшественников несет на поверхности рецептор CD19. Его функции в данном случае не важны; важно то, что собственные T-лимфоциты пациента удалось «научить» узнавать и убивать все клетки, несущие на поверхности такой рецептор. Это, конечно, приводит к гибели не только злокачественных клеток, но и здоровых, нужных для выработки антител, но проблема решается: раз в несколько месяцев поправившимся пациентам вводят внутривенно иммуноглобулины.
На поверхности Т-клеток находятся рецепторы, которые умеют узнавать специальным образом представленные в организме антигены, чаще всего – фрагменты инфекционных агентов. Узнав антиген, лимфоцит начинает активно делиться и выделять в кровь специальные вещества – цитокины, активизирующие другие клетки иммунной системы, способные убивать чужеродные клетки, вызвавшие активацию T-лимфоцитов. Для лечения лейкоза на основе Т-клеточного рецептора из фрагментов нескольких белков удалось создать химерный рецептор, который узнавал вовсе не фрагменты бактерий или вирусов, а рецептор CD19.
Вирус в помощь
Дело оставалось за малым: сделать так, чтобы химерный рецептор появился на поверхности Т-клеток пациента. В арсенале современной молекулярной биологии есть множество средств, позволяющих ввести в клетку нужный ген и заставить его там работать. Чаще других используются средства доставки генов вирусной природы, ведь в природе вирусы делают именно это: проникают в клетки других организмов и встраивают свой геном в хозяйский. Если в геном вируса вставить нужный исследователям ген, то и он окажется в геноме зараженной клетки.
Существующие в природе вирусы за годы использования в лабораториях были сильно модифицированы. Они стали гораздо безопаснее: теперь они могут только заражать клетки, а размножаться внутри зараженных клеток сами по себе не могут. Размножить их для дальнейшего использования можно, используя специальные, культивируемые в лабораториях, клетки и несколько вспомогательных генетических конструкций.
Модифицированный вирус ВИЧ вставляет ген химерного рецептора в геном зараженной клетки.Изо всего множества вирусов, существующих в природе, для модификации Т-клеток лучше всего подходят те вирусы, которые сами по себе обычно заражают именно Т-клетки. Наиболее хорошо изученный среди них – вирус ВИЧ, относящийся к роду лентивирусов. Его модифицированная версия и использовалась для лечения лейкозов. Еще раз подчеркнем, что используемый вирус претерпел множество изменений по сравнению с обычным вирусом ВИЧ и стал практически безопасен. Он уже не обладает способностью воспроизводиться в зараженных клетках и, конечно же, ни при каких обстоятельствах не может вызвать СПИД.
Единственная опасность, связанная с вирусными методами введения генов в T-лимфоциты, заключается в том, что геном вируса встраивается в произвольное место генома зараженной клетки. Встроившись внутрь гена, он может нарушать его работу. В очень редких случаях такое нарушение может приводить к превращению клетки в злокачественную. К сожалению, несколько событий такого рода уже произошли во время более ранних клинических испытаний генной терапии.
Ответная реакция
Разобравшись в конкретных механизмах, рассмотрим эксперимент целиком. На первом этапе из крови пациентов выделяли T-лимфоциты. Затем собственные T-лимфоциты пациентов генетически модифицировались, и на их поверхности появлялись химерные рецепторы. Модифицированные клетки вводились внутривенно обратно пациенту. Встретившись с B-лимфоцитами, несущими рецептор CD19, модифицированные T-лимфоциты их узнавали и дальше вели себя как обычные T-лимфоциты, столкнувшиеся с фрагментом инфекционного агента. Они начинали активно делиться, и при этом образовывалось два типа клеток: короткоживущие эффекторные клетки, вырабатывающие цитокины и непосредственно убивающие B-клетки, и клетки памяти, в небольшом количестве сохраняющиеся в организме всю жизнь и способные в короткие сроки организовать иммунный ответ при повторной встрече с тем же патогеном.
В большинстве случаев B-клетки либо полностью элиминировались из организма, либо их число существенно сокращалось. Многим пациентам удалось вернуться к обычной жизни здоровых людей, лишь раз в несколько месяцев принимая препарат, компенсирующий отсутствие B-лимфоцитов.
Пациенты тяжело переносили лечение: развивалась картина, свойственная для общего воспаления.Пациенты тяжело переносили лечение. Активация Т-лимфоцитов при встрече с патогенами сопровождается выделением ими в кровь цитокинов, запускающих неспецифический иммунный ответ. Развивается картина, свойственная для общего воспаления: у пациента поднимается температура, начинается лихорадка, падает давление, и может даже возникнуть отек легких. Состояние может становиться очень тяжелым.
Состояние Эммы Уайтхед стало даже критическим, но врачам удалось вовремя принять меры. В крови Эммы был обнаружен необычайно высокий уровень одного из цитокинов – интерлейкина 6. Снизить его удалось, дав девочке лекарство, которое обычно используется при лечении ревматоидного артрита – аутоиммунного заболевания, возникающего, когда иммунная система принимает клетки собственного организма за патогены и запускает иммунный ответ против них. Вскоре жизнь Эммы оказалась вне опасности, а еще через некоторое время обнаружилось, что в ее организме не осталось раковых клеток.
Последний шанс
В методе, примененном учеными из Пенсильвании, нет ничего уникального. Аналогичные методы пытаются применять и другие исследователи. Почему же столь значительного успеха добились именно в этом случае? Скорее всего, здесь есть доля везения. Ученым удалось сконструировать удачный рецептор, выбрать эффективный способ доставки и группу заболеваний, против которых такое лечение особенно эффективно.
Участниками клинических испытаний становятся фактически обреченные пациенты.Может показаться странным, что эти результаты преподносятся как значительный успех: ведь пациенты крайне тяжело переносили лечение, да и помогло оно не всем. Все дело в том, что результаты нужно оценивать, помня о том, кто становится участниками клинических испытаний. Как правило, когда пациенту ставится диагноз «лейкоз», сначала проводится химиотерапия. Если химиотерапия не помогает и если находится подходящий донор, следующий вариант лечения – трансплантация костного мозга.
И химиотерапия, и в особенности трансплантация костного мозга – тяжело переносящиеся процедуры с высоким риском осложнений, в том числе фатальных. Если химиотерапия не принесла результатов, а трансплантация костного мозга невозможна или тоже безрезультатна, пациент фактически обречен. Именно такие люди и становятся участниками клинических испытаний. Так что их выздоровление нужно воспринимать как спасение от верной смерти, а риск и тяжесть побочных эффектов нового метода не сильно отличаются от риска и тяжести побочных эффектов стандартных методов лечения.
Смотрите также: Все проблемы тасманийских дьяволов ученые решили в пробирке Требуется миллион клеток, чтобы прочесть раковый геном